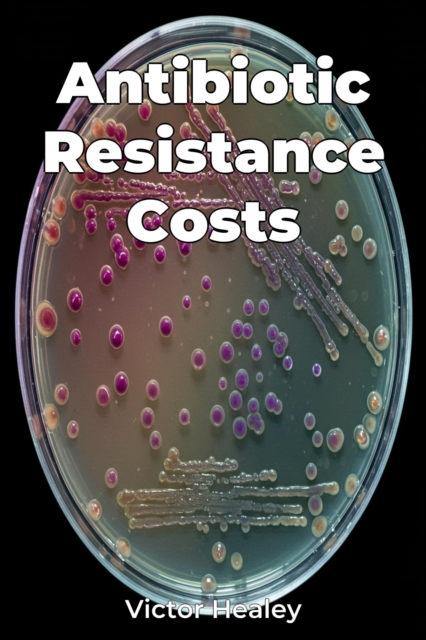
Antibiotic Resistance Costs

Antibiotic Resistance Costs
Antibiotic Resistance Costs reveals the significant economic burden of antibiotic resistance, demonstrating that it is not only a public health issue but also a major economic threat. The book highlights the increased medical costs needed to treat resistant infections, the impact of lost productivity due to illness, and the long-term consequences for economic growth, especially in low- and middle-...
Antibiotic Resistance Costs reveals the significant economic burden of antibiotic resistance, demonstrating that it is not only a public health issue but also a major economic threat. The book highlights the increased medical costs needed to treat resistant infections, the impact of lost productivity due to illness, and the long-term consequences for economic growth, especially in low- and middle-...
